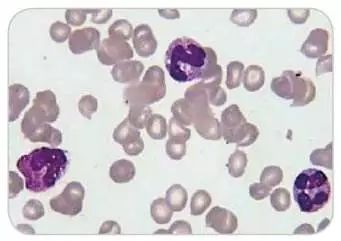

Auer小体:在瑞氏或吉姆萨的血或骨髓涂片中,白细胞胞质中出现染红色细杆状物质,1条或数条不等,长1~6um,称为Auer小体(棒状小体),这种Auer小体可出现在急粒、急单和急粒-单白血病细胞浆内,但不见于急淋白血病,在骨髓增生异常综合征(MDS)的RAEB-t型也可检出。
杜勒小体又称Dohle小体(Dohle body),是中性粒细胞因毒性变化而保留的局部嗜碱性区域,呈圆形、梨形或云雾状,直径为1~2μm,界限不清,可染成灰蓝色,是细胞局部不成熟,即细胞核与细胞质发育不平衡的表现,也是细胞严重毒性变化的表现。常见于严重的感染,如肺炎、败血症和烧伤等。
Chediak-Higashi畸形又称契-东综合征,是Chediak、Higashi分别于1952年和1954年发现,故名Chediak-Higashi综合征。目前约有200例。因其白细胞胞质内有粗大颗粒电子显微镜超微结构和组织化学研究显示,其白细胞内有大块异常颗粒,主要是一种巨大溶酶体,含有多种水解酶。这些异常颗粒主要结合在溶酶体酶上亦可结合在其他细胞上它们使吞噬细胞趋化性减弱杀菌功能缺陷,故患者容易感染。
Alder-Reilly异常:主要的形态特点是白细胞中(包括嗜中性、嗜酸性粒细胞、单核细胞和淋巴细胞)胞浆中含有粗大的染成深蓝色的(嗜天青)颗粒,有的压在核上,易与中毒性颗粒混淆;通常颗粒不多,但仔细观察较易发现。本病为常染色体隐性遗传,是一种粘多糖代谢障碍性疾病。异常颗粒是由于溶酶体缺乏某些水解酶,造成粘多糖和神经鞘磷脂堆集,成为可染色的颗粒。患者常同时伴有脂肪软骨营养不良或Hurler综合症。
May-Hegglin异常:是一种先天性白细胞异常,呈常染色体显性遗传。其特点是在粒细胞及单核细胞胞浆中,出现蓝色的类似杜尔氏体的包涵体。患者常同时伴有巨大血小板,血小板减少、以及轻度出血倾向,但绝大部分人不表现任何症状。
中毒颗粒为中性粒细胞胞质中出现的较粗大、大小不等、分布不均的深蓝色或蓝黑色颗粒。在较严重的化脓性感染、大面积烧伤及恶性肿瘤时多见。

空泡变性也称水肿变性。其特点是在变性细胞的泡浆、胞核内出现大小不一的空泡(水泡),使细胞呈蜂窝状或网状。可在细胞质或核中出现,常为多个,被认为是细胞脂肪变性后未能着色所致;
Russell小体为浆细胞内粘蛋白球形包涵体,含有表面γ-球蛋白,系细胞合成的免疫球蛋白聚集而成。又称cancer小体和fuchsin 小体。浆细胞内数目不一、大小不等的小球体。直径2~3μm,可呈无色、粉红或淡蓝色,它是由浆细胞合成的蛋白质及糖蛋白在内质网凝结堆积而成。见于浆细胞增生性疾病,结核病、类风湿关节炎,淀粉样变性等。
佩尔杰异常症血象(pelger-huet):一种遗传性周围血象中的粒细胞异常症,粒细胞的核叶不超过1-2个,并具有异常粗的核染色质。
R-S细胞见于Hodgkin’s lymphoma(霍奇金淋巴瘤),是霍奇金淋巴瘤含有的一种体积较大的独特的瘤巨细胞即Reed-Sternberg细胞(简称R-S细胞),典型的R-S细胞是一种直径20~50μm或更大的双核或多核的瘤巨细胞。瘤细胞呈椭圆形,胞浆丰富,稍嗜酸性或嗜碱性,细胞核圆形,呈双叶或多叶状,以致细胞看起来像双核或多核细胞,形态相同状如鹰眼及所谓“镜影”核。染色质粗糙,沿核膜聚集呈块状,核膜厚而清楚。核内有一非常大的,直径与红细胞相当的,嗜酸性的中位核仁,周围有空晕。
版权归原作者所有,如有违规、侵权请联系我们